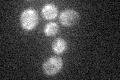

View description
Subunit a of the vacuolar-ATPase V0 domain, one of two isoforms (Stv1p and Vph1p); Stv1p is located in V-ATPase complexes of the Golgi and endosomes while Vph1p is located in V-ATPase complexes of the vacuole
Localization:
Intensity:
Fold change:
Significance:
-
C’ GFP library in SD

below threshold15.87 -
N' NOP1pr-GFP in SD

punctate70.481 -
N' TEF2pr-mCherry in SD

punctate48.3256 -
N' NATIVEpr-GFP in SD

punctate26.3174 -
N' TEF2pr-VC and Cyto-VN in SD

below threshold29.6583 -
C’ GFP library in SD+DTT

cytosol14.020.88No -
C’ GFP library in SD+H2O2
cytosol14.750.92No -
C’ GFP library in Starvation Media

cytosol14.960.94No -
C’ GFP library on the background of Pup2-DaMP

below threshold -
C’ GFP library on the background of CCT mutant

below threshold14.51360.914314No
